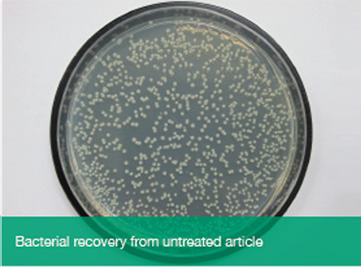

Ultra-Fresh CA-16 is a fine powder used in the treatment of polymers, synthetic fibers, coatings and adhesives to reduce the effects of microbial action such as odor generation, degradation or discoloration.
Utilizing the natural antimicrobial properties of silver, Ultra-Fresh CA-16 can be incorporated into a wide range of polymer materials to prolong their life, maintain their aesthetic appeal and reduce surface bioburden.
Ultra-Fresh CA-16 is compatible with all types of polymer manufacturing processes including injection or rotational moulding, extrusion, blown film, calendaring or coating and can be applied by direct addition or in the form of a masterbatch concentrate when required.




Some examples of Ultra-Fresh CA-16 end uses:
Cooler bags & containers
Nonwovens
PVC films & PU coatings
Toothbrush Bristles
Hand Driers
PA, PP & PET Fibers
Sanitary Washroom Bins
Towel Dispensers
Kitchen Cutting Boards
Pipes and tubing
Soap Dispensers
Washroom Driers
Mattress Foam
Powder Coatings
Synthetic Rubber Elastomers
Water Tanks